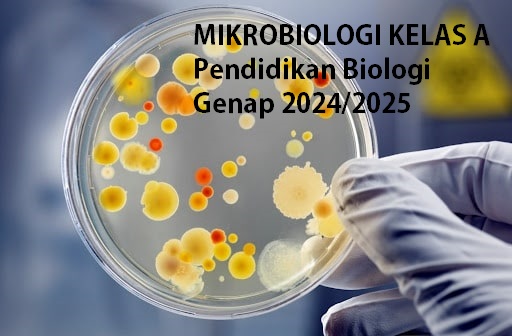
PSPB_Mikrobiologi_Kelas A_Genap 2024/2025

Enrolment options
Sebagai mata kuliah wajib di Jurusan Pendidikan MIPA Universitas Lampung, dengan beban sks 3 (2-1), untuk mahasiswa semester 3. Mata kuliah ini bertujuan untuk membahas prinsip-prinsip dalam mikrobiologi yang meliputi : sejarah perkembangan mikrobiologi, ciri-ciri mikroba, alga, protozoa, fungi, virus, bakteri, nutrisi dan media tumbuh mikroba, reproduksi dan pertumbuhan mikroba, bioenergi, biosintesis, genetika mikroba, imunologi dasar, mikrobiologi lingkungan dan mikrobiologi terapan. Proses pembelajaran: kuliah dan praktikum
- Teacher: Wisnu Juli
- Enrolled students: 35